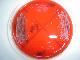
Thumbnail

Mostrar el registro sencillo del ítem
DIAGNÓSTICO LABORATORIAL DE INFECÇÕES CONJUNTIVAIS BACTERIANAS: TRATAMENTO EMPÍRICO OU NÃO?
| dc.contributor.advisor | Antunes, Ana Lucia Souza | pt_BR |
| dc.contributor.author | Brandelli, Clara Lia Costa | pt_BR |
| dc.contributor.other | Freitas, Ana Lucia Peixoto de | pt_BR |
| dc.contributor.other | Massi, Lisandra Silvani | pt_BR |
| dc.date.accessioned | 2019-12-18T11:32:58Z | pt_BR |
| dc.date.issued | 2006 | pt_BR |
| dc.identifier.uri | http://hdl.handle.net/10183/202912 | pt_BR |
| dc.format.mimetype | image/jpeg | pt_BR |
| dc.format.mimetype | application/pdf | pt_BR |
| dc.language.iso | por | pt_BR |
| dc.relation.ispartof | Salão de Extensão (07. : 2006 : Porto Alegre, RS). Caderno de resumos. Porto Alegre : UFRGS/PROREXT, 2006. | pt_BR |
| dc.rights | Open Access | en |
| dc.subject | Células queratinizadas | pt_BR |
| dc.subject | Citológico conjuntival | pt_BR |
| dc.subject | Secreção conjuntival | pt_BR |
| dc.subject | Resistência bacteriana | pt_BR |
| dc.title | DIAGNÓSTICO LABORATORIAL DE INFECÇÕES CONJUNTIVAIS BACTERIANAS: TRATAMENTO EMPÍRICO OU NÃO? | pt_BR |
| dc.type | Resumo publicado em evento | pt_BR |
| dc.contributor.event | Salão de Extensão (07. : 2006 set. 24-27: UFRGS, Porto Alegre, RS) | pt_BR |
| dc.subject.theme | Saúde | pt_BR |
| dc.type.presentation | Comunicação Oral | pt_BR |
| dc.identifier.extensao | 8108 | pt_BR |
Ficheros en el ítem
Este ítem está licenciado en la Creative Commons License
-
Salud (145)